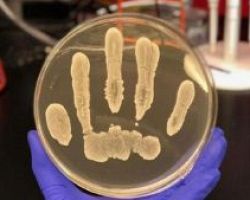

Με αμείωτο ρυθμό συνεχίζεται η επιδημία ιλαράς στη χώρα μας. Σύμφωνα με τη νέα επιδημιολογική έκθεση του Κέντρου Ελέγχου και […]
Δημοσιεύτηκε στις 29 Μαρτίου, 2018

Την 1η Απριλίου 2018 ξεκινάει η νέα εμβολιακή καμπάνια των αλεπούδων για ανοσοποίηση έναντι του ιού της Λύσσας,. Από το […]
Δημοσιεύτηκε στις 29 Μαρτίου, 2018

Δυο εξαιρετικά σημαντικά έργα εξοπλισμού του νοσοκομείου «Άγιος Παύλος» στην ανατολική Θεσσαλονίκη, αλλά και τεσσάρων κέντρων υγείας 25ης Μαρτίου, Τούμπας, […]
Δημοσιεύτηκε στις 21 Μαρτίου, 2018

Σε εξέλιξη βρίσκεται η επιδημία ιλαράς που έχει εκδηλωθεί σε πολλές Ευρωπαϊκές χώρες. Περισσότερα από 20.000 περιστατικά ιλαράς έχουν καταγραφεί […]
Δημοσιεύτηκε στις 13 Μαρτίου, 2018

Παράδειγμα προς μίμηση ο Διευθυντής και οι διοικητικοί υπάλληλοι της ΔΙΕΎΘΥΝΣΗΣ Α/ΘΜΙΑΣ ΕΚΠΑΙΔΕΥΣΗΣ ΗΜΑΘΙΑΣ. Εγγράφηκαν ΟΛΟΙ ως Εθελοντές Δότες Μυελού […]
Δημοσιεύτηκε στις 13 Μαρτίου, 2018

Είμαστε η πρώτη χώρα στην Ευρώπη σε εισαγωγές ακριβών φαρμάκων και η τελευταία σε χρήση οικονομικών γενοσήμων, επισημαίνει σε συνέντευξή […]
Δημοσιεύτηκε στις 12 Μαρτίου, 2018

Η Διεύθυνση Δευτεροβάθμιας Εκπαίδευσης Πέλλας, σε συνεργασία με το Διοικητή του Γενικού Νοσοκομείου Πέλλας, την Περιφερειακή Ενότητα Πέλλας, τις Α΄ […]
Δημοσιεύτηκε στις 12 Μαρτίου, 2018

Τι είναι οι βηματοδότες; Τι είναι οι απινιδωτές; Πώς ζουν και πώς είναι η ποιότητα των ασθενών που υποβλήθηκαν σε επέμβαση […]
Δημοσιεύτηκε στις 9 Μαρτίου, 2018

Μια ουσιαστική και συγκινητική ημερίδα ενημέρωσης και ευαισθητοποίησης μαθητών/τριών Λυκείων για τη δωρεά μυελού των οστών διοργανώθηκε από τη Διεύθυνση […]
Δημοσιεύτηκε στις 7 Μαρτίου, 2018
Το πρώτα επιβεβαιωμένα κρούσματα του ιού της γρίπης καταγράφηκαν σε επίπεδο Κρήτης. Όσον αφορά στο πρώτο κρούσμα, πρόκειται για έναν […]
Δημοσιεύτηκε στις 6 Μαρτίου, 2018